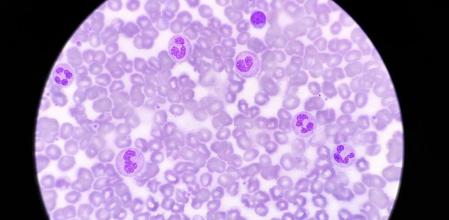
Horizontal

La agranulocitosis, neutropenia o granulocitopenia es una enfermedad de la sangre que se produce cuando el recuento de granulocitos sanguíneos es bajo (neutrófilos, eosinófilos y basófilos) y disminuye la capacidad del cuerpo de combatir los gérmenes, y con ello, las infecciones. Hasta las bacterias que viven normalmente en la boca o en el sistema digestivo pueden ser potencialmente infecciosas en un caso de agranulocitosis. Es una enfermedad poco frecuente pero puede ser grave y hasta fatal en algunos casos. Se produce agranulocitosis cuando el número de neutrófilos es menor a 1.000 – 1.500 células /milímetro cúbico de sangre.
Puede ser:
- Leve: número de neutrófilos es menor a 1.000 – 1.500 células /milímetro cúbico de sangre.
- Moderada: número de neutrófilos es menor a 500 – 1.000 células /milímetro cúbico de sangre.
- Grave: número de neutrófilos es menor a 500 células /milímetro cúbico de sangre.
Causas de la agranulocitosis
Diversos trastornos, fármacos y otras causas
La agranulocitosis puede ser causada por diversos motivos pero los dos principales son:
- Destrucción o uso de neutrófilos más rápida que la capacidad de la médula ósea para producir células nuevas.
- La producción de neutrófilos en la médula ósea se reduce.
En el primer caso la destrucción de neutrófilos o sobreuso ocurre por la aparición de trastornos como:
- Infecciones bacterianas: salmonelosis.
- Alergias.
- Tratamientos farmacológicos: algunos medicamentos como los usados para el tratamiento del hipertiroidismo como metimazol y propiltiouracilo; antibióticos como vancomicina, penicilina G y oxacilina; antivirales como ganciclovir y valganciclovir; antipsicóticos como clozapina y clorpromazina.
- Trastornos inmunitarios: granulomatosis con poliangitis, lupus y artritis reumatoide.
En el segundo caso puede ser consecuencia de:
- Un cáncer.
- Infecciones víricas: varicela, Epstein-Barr, hepatitis A, B y C, VIH y sarampión.
- Tratamiento de radioterapia o quimioterapia.
- Trastornos de la médula ósea: anemia aplásica. Síndromes mielodisplásicos o mielofibrosis.
Otras causas:
- Síntoma de Kostmann. También llamado neutropenia congénita severa, agranulocitosis congénita, agranulocitosis de Kostmann o neutropenia severa infantil.
- Carencia de vitaminas o desnutrición.
- Anormalidades del bazo.
- Neutropenia crónica idiopática (de origen desconocido).
Síntomas de la agranulocitosis
No tiene síntomas específicos
Esta enfermedad no tiene síntomas específicos por lo que es importante consultar con el médicos si se produce un cuadro con estos signos:
- Fiebre de 38ºC o más.
- Escalofríos y sudor.
- Tos grave.
- Falta de aliento.
- Llaga o llagas en la boca.
- Dolor en la garganta.
- Cambios al orinar.
- Rigidez en el cuello.
- Vómitos.
- Diarrea.
- Enrojecimiento o inflamación en una lesión de la piel (corte o arañazo).
-Secreciones vaginales anormales.
- Dolores óseos.
- Debilidad general.
Diagnóstico de la agranulocitosis
Infecciones frecuentes y poco usuales
Los médicos no suelen sospechar de agranulocitosis a menos que el paciente padezca infecciones frecuentes y poco usuales. El especialista solicitará un análisis de sangre en el que el recuento bajo de neutrófilos indicará agranulocitosis o neutropenia. También se puede realizar una radiografía de tórax, un estudio de anticuerpos de neutrófilos, una biopsia de la médula ósea, una biopsia de las úlceras bucales o un cultivo de orina.
Si el paciente tiene malestar abdominal se puede hacer una tomografía computerizada (TC).
Tratamiento y medicación de la agranulocitosis
Eliminar la causa
El tratamiento se orienta a eliminar la causa que produce la agranulocitosis o neutropenia. El tratamiento depende, por supuesto, de cada caso y de su gravedad. Si es por causa farmacológica se retira el tratamiento que produce la enfermedad. Si hay infección se suministrarán al paciente antibióticos eficaces contra los microorganismos infecciosos más comunes. Si la causa es un trastorno autoinmune los corticoesteroides pueden ser eficaces. La inmunoglobulina antitimocítica, vía intravenosa, puede combatir la agranulocitosis si existe anemia aplásica.
El trasplante de médula ósea solo tiene utilidad para tratar la leucemia o la anemia aplásica que llegan a producir agranulocitosis o neutropenia.
Prevención de la agranulocitosis
Sin prevención
La agranulocitosis no se puede prevenir excepto en los casos en que el motivo sea una desnutrición. En ese caso seguir una dieta equilibrada y saludable con suficiente ingesta de vitaminas puede ser preventiva. Aparte, si se está siguiendo un tratamiento con fármacos que pueden provocar una agranulocitosis se debe consultar con el médico prescriptor.